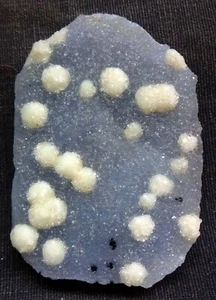
STUNNTING FLURIOTE BALLS ON CHALSEDONY MATRIX MINERALS SPECIMEN+25.1 - Picture 1 of 3

Picture 1 of 3

Gallery
Picture 1 of 3



Have one to sell?
STUNNTING FLURIOTE BALLS ON CHALSEDONY MATRIX MINERALS SPECIMEN+25.1
Condition:
Oops! Looks like we're having trouble connecting to our server.
Refresh your browser window to try again.
Shipping:
Free Standard Shipping from India.
Located in: DEOLALI, MAHARASHTRA, India
Delivery:
Estimated between Wed, 19 Nov and Fri, 5 Dec to 94104
Returns:
30 days return. Buyer pays for return shipping. If you use an eBay shipping label, it will be deducted from your refund amount.
Coverage:
Read item description or contact seller for details. See all detailsSee all details on coverage
(Not eligible for eBay purchase protection programmes)
Seller assumes all responsibility for this listing.
eBay item number:406335319346
Item specifics
- Condition
- New: A brand-new, unused, unopened, undamaged item. See the seller's listing for full details. See all condition definitionsopens in a new window or tab
- Country of Origin
- India
- WEIGHT:
- WEIGHT: 30 GRAM
- SIZE:
- SIZE: 6X4 CM
About this product
Product Identifiers
Brand
Crystal Allies
UPC
0849344021032
eBay Product ID (ePID)
1619664329
Dimensions
Weight
255 Hundredths Pounds
Item description from the seller
Popular categories from this store
Seller feedback (58)
- r***a (1939)- Feedback left by buyer.Past 6 monthsVerified purchaseSuper Fast Shipping, Item as Described, Smooth Transaction, An Asset to EBay! Five Stars 🌟 All Around!! Packaged safely and securely. Good deal on a beautiful Gyrolite specimen. I absolutely love this aesthetic small cabinet piece!! Excellent service and communication. I'd recommend purchasing from this seller based on this experience
- 2***_ (10)- Feedback left by buyer.Past 6 monthsVerified purchaseExactly as described. Well packed and fast shipping. Thank you!GREEN APOPHYLLITE CRYSTALS W/ CALCITE QUARTZ ON MATRIX MINERALS SPECIMENS (#405977711754)
- 0***i (92)- Feedback left by buyer.Past yearVerified purchaseItem I received is exactly as shown. Sale photos are much darker, but the piece is exquisite! Great value. Arrived in great condition, care with packaging. Excellent pieces for anyone who collects. Stunning items!STUNNING APOPHYLLITE CUBES W/ STILBITE ON MATRIX MINERALS SPECIMEN-B (#405693641145)
More to explore :
- Crystals & Mineral Specimens,
- Rare Crystal & Mineral Specimens,
- Crystal & Mineral Display Specimens,
- Other Crystals & Mineral Specimens,
- Bixbyites Display Specimens,
- BALL Collectible Jars,
- Collectible Holiday & Seasonal Ornaments Balls,
- Dragon Ball Manga,
- Dragon Ball Collectible Figures & Bobbleheads,
- Pop! Dragon Ball Vinyl Collectible Figures & Bobbleheads

